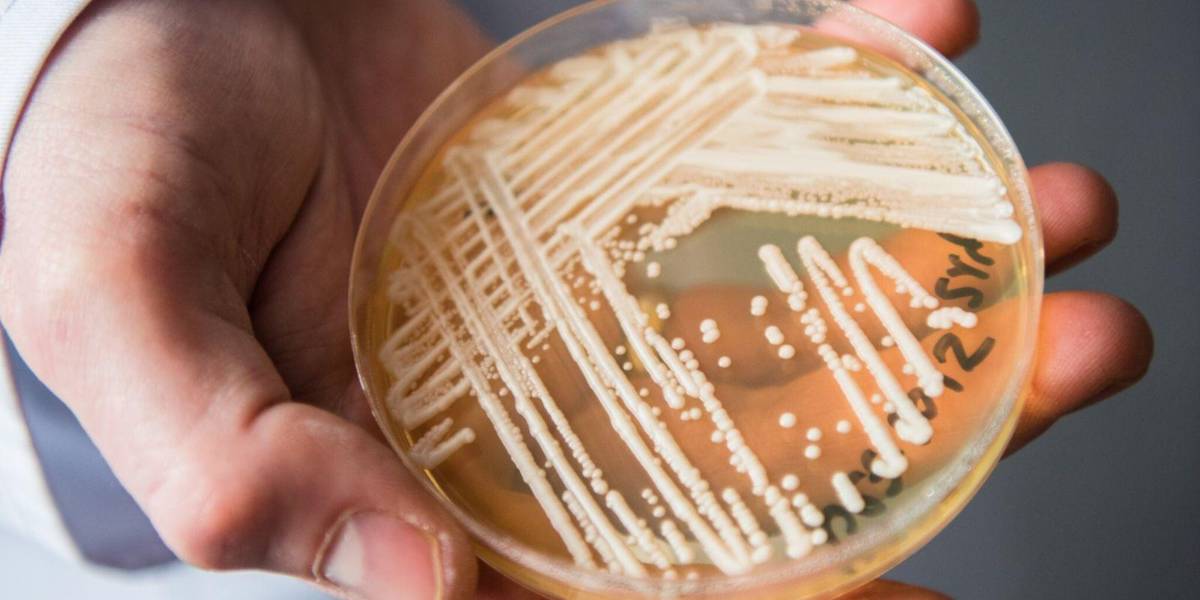

Candida Auris: este es el hongo que contrajo Javier Acosta, el influencer colombiano que recibirá eutanasia
El joven habría contraído la infección en una piscina en Melgar, en 2015.
-
 Imagen referencial de Candida Auris.( )
Imagen referencial de Candida Auris.( )
El reciente caso de Javier Acosta, el joven bogotano que contrajo la infección por Candida Auris y cuya complicación lo ha llevado a tomar la decisión de realizarse eutanasia este viernes, 30 de agosto, ha generado preocupación sobre la propagación de este hongo resistente a los medicamentos.
Lea: La conmovedora carta que escribió Javier Acosta buscándole un hogar a su perrita
El portal de salud MedlinePlus informa que, según el Centro de Control y Prevención de Enfermedades (CDC), Candida Auris es un hongo que puede causar infecciones graves, especialmente en personas con sistemas inmunitarios debilitados, como pacientes con cáncer, VIH/SIDA o aquellos que han recibido trasplantes de órganos. Además su principal característica es su resistencia los antibióticos.
La infección por Candida Auris puede transmitirse a través del contacto con superficies contaminadas, equipos médicos no desinfectados y el contacto personal con personas infectadas, este hongo es común en ancianatos u hospitales. Además, el hongo puede sobrevivir en superficies durante semanas, lo que facilita su propagación, como lo indica el Centro Oncológico Memorial Sloan Ketter.
Los hongos pueden causar infecciones al ingresar al torrente sanguíneo por heridas abiertas o cuando las defensas del organismo están bajas.
“Ese hongo le puede dar a cualquier persona, pero en cinco días tenía una llaga que se me pasó al hueso del glúteo izquierdo y luego al derecho. Y ahí empezó todo. La infección comenzó a agrandarse”, relató Javier Acosta.
La infección se complicó, derivando en osteomielitis, una grave infección ósea y, posteriormente, en un cáncer en la sangre (leucemia). Acosta describió el dolor como insoportable, a pesar del tratamiento con morfina. Además el hongo ya había llegado hasta su cerebro, lo que le imposibilitaría el habla próximamente.
La presencia de hongos en las piscinas
Puede interesarle: Javier Acosta, quien se someterá a la eutanasia este viernes, recibe un emotivo gesto de Radamel Falcao
La falta de desinfección y limpieza en piscinas abiertas al público puede convertirlas en un caldo de cultivo para la proliferación de hongos y bacterias. Estos pueden propagarse a escaleras, bordes de las piscinas e incluso duchas.
Por ello, algunas recomendaciones pueden ayudar a prevenir una infección por hongos o bacterias. Entre ellas:
Recomendadas